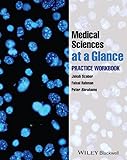
Amazon cover image

Medical sciences at a glance : practice workbook / edited by Michael D. Randall.
Series: At a glance series (Oxford, England)Publisher: Chichester, West Sussex : John Wiley & Sons, 2014Copyright date: ©2014Description: 122 pages : illustrations ; 27 cmContent type:- text
- unmediated
- volume
- 9780470654491
| Item type | Current library | Home library | Collection | Call number | Materials specified | Copy number | Status | Date due | Barcode | |
|---|---|---|---|---|---|---|---|---|---|---|
| AM | PERPUSTAKAAN DR ABDUL LATIFF | PERPUSTAKAAN DR ABDUL LATIFF KOLEKSI AM-P. DR ABDUL LATIFF | - | WB100.M4892 2014 9 (Browse shelf(Opens below)) | 1 | Available | 00002123185 | |||
| AM | PERPUSTAKAAN PRAKLINIKAL | PERPUSTAKAAN PRAKLINIKAL KOLEKSI AM-P. PRAKLINIKAL | - | WB100.M4892 2014 9HUKMPRA (Browse shelf(Opens below)) | 1 | Available | 00002128015 |
Browsing PERPUSTAKAAN PRAKLINIKAL shelves, Shelving location: KOLEKSI AM-P. PRAKLINIKAL Close shelf browser (Hides shelf browser)

|

|

|

|

|

|

|
||
| WB100.M489 2014 9HUKMPRA Medical sciences at a glance / | WB100.M489 2015 9HUKMPRA Medical sciences / | WB100.M489 2019 9HUKMPRA Medical sciences / | WB100.M4892 2014 9HUKMPRA Medical sciences at a glance : practice workbook / | WB100.O98 2020 9HUKMPRA Oxford textbook of medicine / | WB100.O98 2020 9HUKMPRA Oxford textbook of medicine / | WB100.O98 2020 9HUKMPRA Oxford textbook of medicine / |
Buku ini pakej bersama buku Medical sciences at a glance, ISBN set 9781118892640.
There are no comments on this title.
Log in to your account to post a comment.